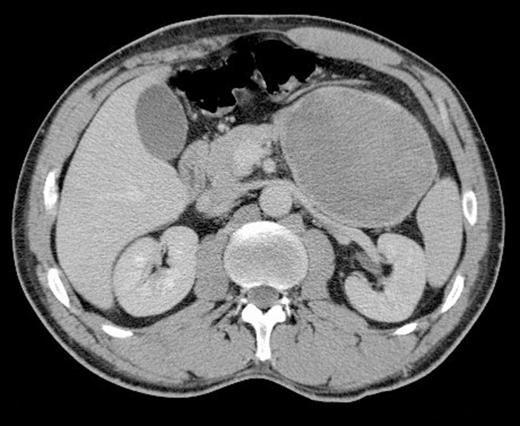
Axial CT scan showing a large lesion related to the stomach in the left upper quadrant

-
PDF
- Split View
-
Views
-
Cite
Cite
J Barnes, G Bouras, L Cooper, FT Lam, J Shearman, V Menon, Splenic artery aneurysm presenting with clinical features of a bleeding gastric gastrointestinal stromal tumour, Journal of Surgical Case Reports, Volume 2011, Issue 6, June 2011, Page 1, https://doi.org/10.1093/jscr/2011.6.1
Close - Share Icon Share
Abstract
Gastrointestinal stromal tumours often present with insidious upper gastrointestinal symptoms. Initial definitive diagnosis can be difficult and therefore misdiagnosis is not infrequent. Here we report a case of upper GI bleeding caused by a splenic artery aneurysm that was misdiagnosed as a gastric GIST. This rare presentation of splenic artery aneurysm highlights the potential pitfalls of investigation in upper gastrointestinal disease.
INTRODUCTION
Gastrointestinal stromal tumours (GIST) are neoplastic lesions of the gastrointestinal tract that commonly arise in the stomach and are being diagnosed with increasing frequency. The diagnosis is often made at gastroscopy although some lesions are detected through imaging. The grade of GIST can vary and is assessed using the mitotic index from histology (1). High grade GIST are uncommon and tend to be large at presentation with invasion into other organs and/or metastases.
Patients with GIST frequently present with insidious upper gastrointestinal symptoms. Endoscopy reveals a mural lesion with normal mucosal biopsies. Radiology is often more precise in assessing tumour size and position. Once diagnosed, elective surgical resection is recommended and allows for the assessment of tumour grade and malignant risk. Less commonly, GIST can present acutely with gastrointestinal bleeding. Several atypical presentations of malignant GIST such as hypoglycaemia and testicular mass have also been described (2,3). In addition, several others have reported misdiagnosis of non-neoplastic abdominal lesions as GIST (4,5,6). With increasing molecular characterization of such lesions, the presentation, management and treatment of GIST is of interest to surgical oncologists worldwide.
Here we describe our experience with one patient who had endoscopic features typical of a bleeding gastric GIST that was subsequently found to have an atypical splenic artery aneurysm at laparotomy.
CASE REPORT
A 32 year old professional footballer was assessed having suffered presyncope and haematemesis whilst driving. Initial tests revealed a haemoglobin of 9g/dl, a white cell count of 17 000/ml and a C-reactive protein of 212mg/l. Upper gastrointestinal endoscopy revealed a protruding lesion in the gastric fundus with a haemorrhagic ulcer at its apex (Figure 1).

A subsequent CT scan showed an 18cm x 8cm mass related to the stomach that was displacing other organs in the left upper quadrant (Figure 2). The scan also revealed the presence of a small splenic aneurysm separate to this lesion.
Axial CT scan showing a large lesion related to the stomach in the left upper quadrant
The diagnosis of bleeding gastric GIST was made based on these findings and the patient was consented for laparotomy. During surgery, a large heterogenous mass was found encasing the gastric fundus, colon and the tail of pancreas (Figure 3).

The decision was made to perform an en-bloc resection with distal pancreatectomy, splenectomy, segmental colectomy with primary anastomosis, and gastric wedge resection (Figure 4). The patient made an uncomplicated recovery from surgery. Histological analysis of the resected specimen revealed a prominent histiocytic inflammatory reaction surrounding a splenic artery aneurysm with no features of gastrointestinal neoplasia.

DISCUSSION
True aneurysms of the splenic artery are rare outside of pregnancy, yet are still the 3rd most common abdominal aneurysm (after aortic and iliac). They are more common in the elderly and the incidence ranges from 0.01% to 10.4%. In approximately 30% of cases, the aneurysm ruptures into an adjacent viscous (7). Aneurysms of the coeliac, hepatic and mesenteric arteries have been previously reported to present with gastrointestinal bleeding (8). There are two accounts of gastrointestinal bleeding associated with splenic artery aneurysms however these caused colonic and pancreatic bleeding (7,8). The present report adds to the literature by describing for the first time a splenic artery aneurysm bleeding into the gastric fundus and mimicking the endoscopic appearance of a bleeding gastric GIST.
This case differs from other accounts as there was a soft tissue reaction surrounding a small splenic artery aneurysm and therefore the appearances were similar to a neoplastic mass. This inflammatory phlegmon is presumed to be associated with a vasculitic process surrounding the splenic artery aneurysm as reflected by the initial raised inflammatory markers. Such vascular changes are often associated with systemic vasculitic conditions and in particular polyarteritis nodosum which causes necrotising inflammation of medium and small sized arteries. In the present report, however, there was no evidence of systemic vasculitis and the disease was therefore focal and isolated.
Ironically, the endoscopic misdiagnosis in this case hastened surgical intervention. Without insidious bleeding as a warning sign, this patient may have subsequently suffered rupture and torrential bleeding. This article reports on a rare mode of presentation of splenic artery aneurysm that may interest surgeons and endoscopists that manage gastrointestinal bleeding. The management of this case highlights potential pitfalls in radiological and endoscopic diagnosis which must be taken into account when dealing with similar cases in the future.